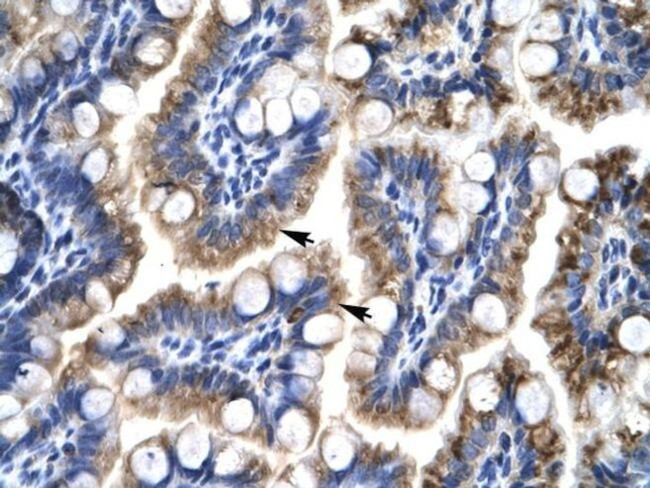
ATF5 Antibody in Immunohistochemistry (IHC)

Search
Invitrogen
ATF5 Polyclonal Antibody
{{$productOrderCtrl.translations['antibody.pdp.commerceCard.promotion.promotions']}}
{{$productOrderCtrl.translations['antibody.pdp.commerceCard.promotion.viewpromo']}}
{{$productOrderCtrl.translations['antibody.pdp.commerceCard.promotion.promocode']}}: {{promo.promoCode}} {{promo.promoTitle}} {{promo.promoDescription}}. {{$productOrderCtrl.translations['antibody.pdp.commerceCard.promotion.learnmore']}}
产品信息
PA5-46842
宿主/亚型
分类
类型
抗原
偶联物
形式
浓度
规格
保存条件
运输条件
RRID
产品详细信息
Peptide sequence: MSLLATLGLE LDRALLPASG LGWLVDYGKL PPAPAPLAPY EVLGGALEGG
Sequence homology: Cow: 85%; Human: 100%; Mouse: 85%; Pig: 85%; Rat: 85%
靶标信息
ATF5 is a protein coding gene. Transcription factor that either stimulates or represses gene transcription through binding of different DNA regulatory elements such as cAMP response element (CRE) (consensus: 5'-GTGACGT[AC][AG]-3'), ATF5-specific response element (ARE) (consensus: 5'-C[CT]TCT[CT]CCTT[AT]-3') but also the amino acid response element (AARE), present in many viral and cellular promoters. Critically involved, often in a cell type-dependent manner, in cell survival, proliferation, and differentiation. Its transcriptional activity is enhanced by CCND3 and slightly inhibited by CDK4. Important regulator of the cerebral cortex formation, functions in cerebral cortical neuroprogenitor cells to maintain proliferation and to block differentiation into neurons. Must be down-regulated in order for such cells to exit the cycle and differentiate. Participates in the pathways by which SHH promotes cerebellar granule neuron progenitor cells proliferation. Critical for survival of mature olfactory sensory neurons (OSN), directs expression of OSN-specific genes. May be involved in osteogenic differentiation. Promotes cell proliferation and survival by inducing the expression of EGR1 sinergistically with ELK1. Once acetylated by EP300, binds to ARE sequences on target genes promoters, such as BCL2 and EGR1. Plays an anti-apoptotic role through the transcriptional regulation of BCL2, this function seems to be cell type-dependent. Cooperates with NR1I3/CAR in the transcriptional activation of CYP2B6 in liver. In hepatic cells, represses CRE-dependent transcription and inhibits proliferation by blocking at G2/M phase. May act as a negative regulator of IL1B transduction pathway in liver. Upon IL1B stimulus, cooperates with NLK to activate the transactivation activity of C/EBP subfamily members. Besides its function of transcription factor, acts as a cofactor of CEBPB to activate CEBPA and promote adipocyte differentiation. Regulates centrosome dynamics in a cell-cycle- and centriole-age-dependent manner. Forms 9-foci symmetrical ring scaffold around the mother centriole to control centrosome function and the interaction between centrioles and pericentriolar material.
仅用于科研。不用于诊断过程。未经明确授权不得转售。